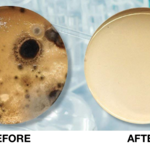

Serving Orlando, FL and surrounding areas
Approved
In business since 2002
Free estimates
Credit card accepted
"Mold Test America was outstanding. I live in Chicago and was requesting Mold Test America to check my Double wide home in Largo, Fla. Dwayne walked me though the procedure and after agreeing to the price and testing, they took care of all the rest. Within 3-4 days they tested my property and sent the tests to a mold laboratory. Within a few days or so I was sent the result per email. Also, within a week I was forwarded a hard copy. Following the results, I followed up with questions via phone. Dwayne walked me through the results and and provided me with advice. All in all---an outstanding company and I personally recommend Mold Test America."





+3